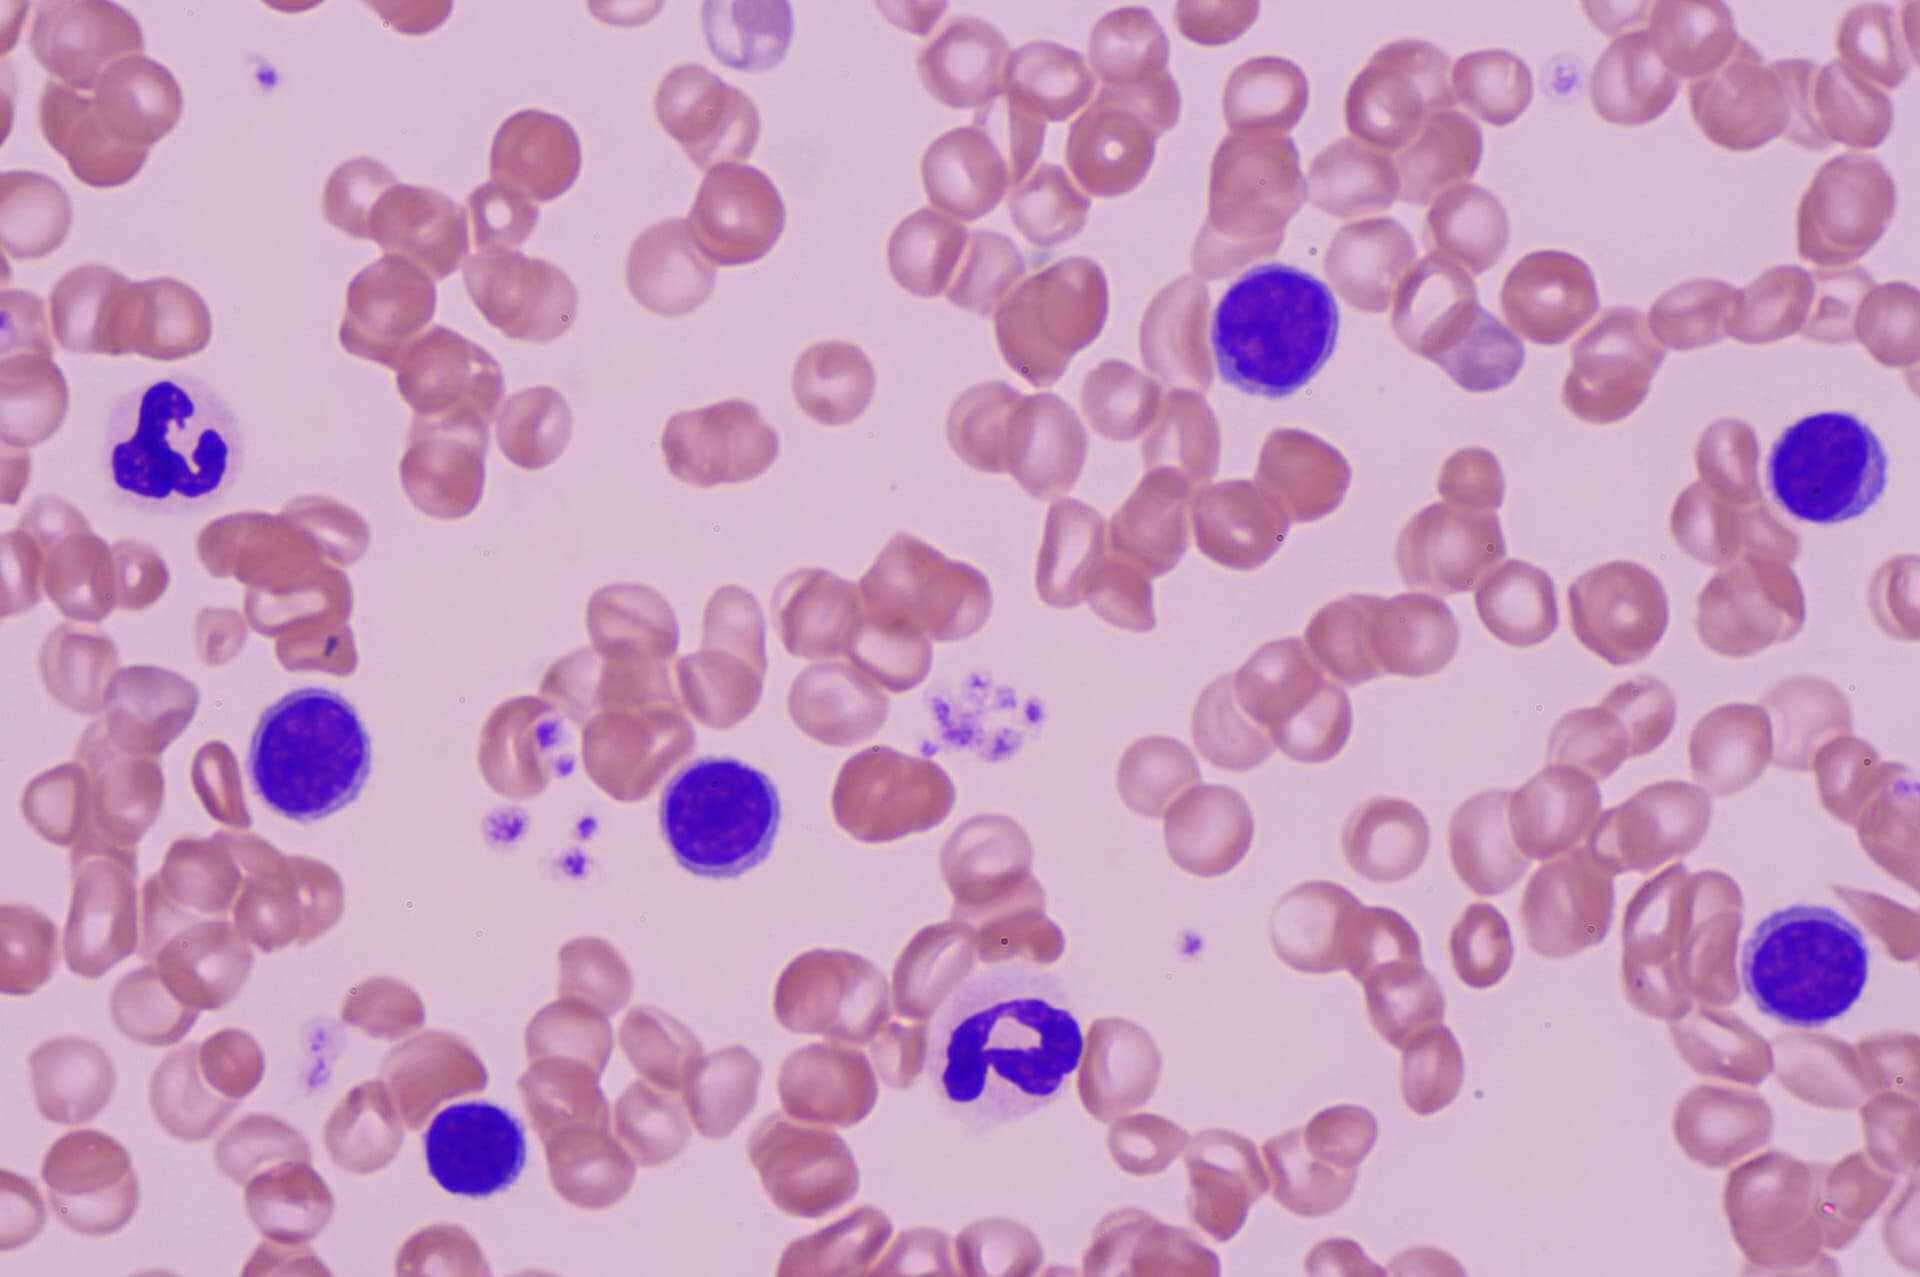

治療実績
WORKS
リンパ球性白血病 |
|---|
血液の写真
白血球数が多いワンちゃんです。白血球の中のリンパ球が多いことがわかりました。紫の丸い細胞が「リンパ球」です。形は正常ですが、異常に多くあります。
様々な検査で、「リンパ球性白血病」と診断しました。この白血病はそれほど珍しくはありません。健康診断の血液検査で見つかることが多いです。
症状はなく、元気ですので、経過観察です。
受付時間
| 受付時間 | 月 | 火 | 水 | 木 | 金 | 土 | 日祝 |
|---|---|---|---|---|---|---|---|
| 9:50-12:45 | ○ | ○ | 休 | ○ | ○ | ○ | ○ |
| 15:50-18:45 | ○ | ○ | 休 | ○ | ○ | ○ | ○ |
水曜休診
夏季休業なし
12月30日から1月3日休診

